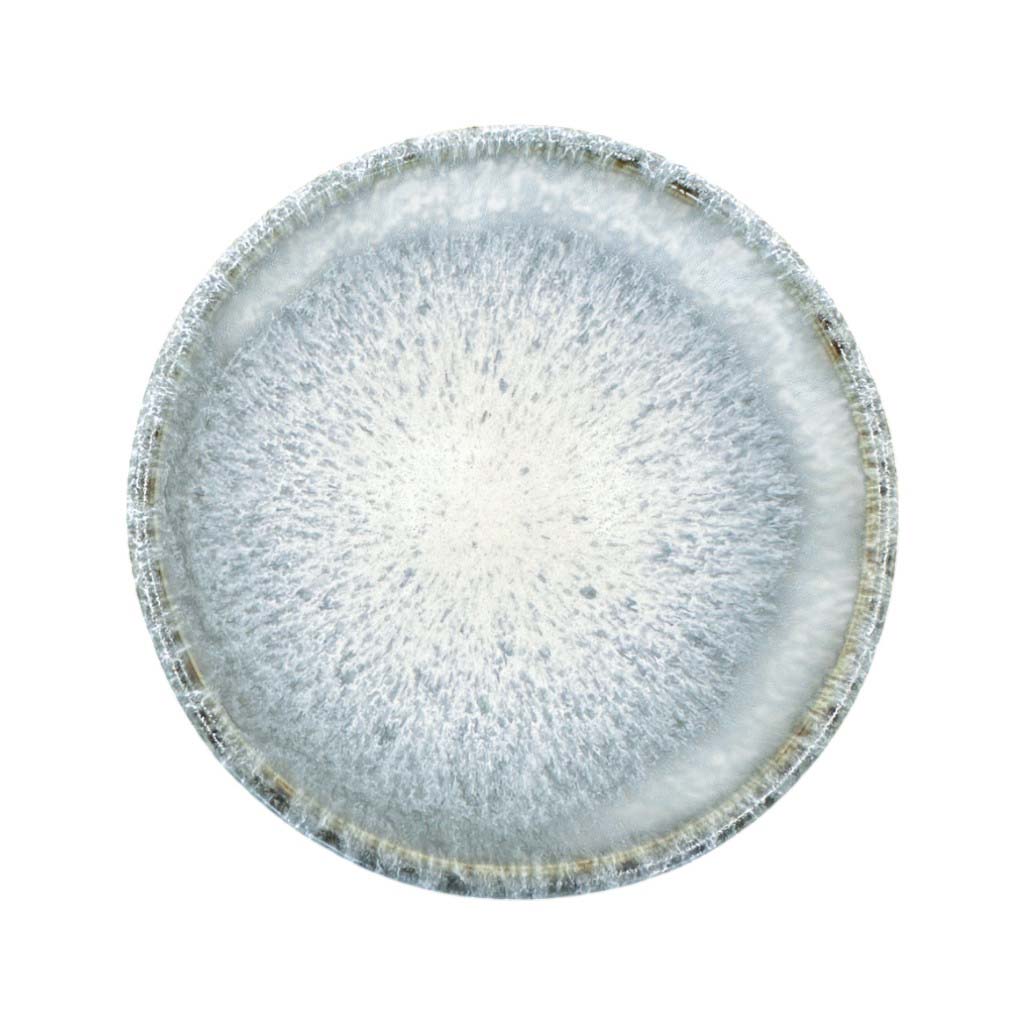

soñho Anoitecer Minischale, 200 ml
CHF 14.90
Grundpreis
/
Nicht verfügbar
Die Anoitecer Minischale bringt die feine Eleganz der Dämmerung auf den Tisch. Ihr grau-weiss gesprenkeltes Design erinnert an den sanften Übergang von Tag zu Nacht – ruhig, harmonisch und zeitlos schön. Perfekt für kleine Köstlichkeiten, Gewürze oder Dips, fügt sich diese handgefertigte Schale mühelos in jede Tischkultur ein. Die feine Glasur macht jedes Stück zu einem Unikat, das den Blick auf das Wesentliche lenkt. Mit Anoitecer wird selbst das kleinste Detail zum bewussten Genussmoment – schlicht, natürlich und voller Atmosphäre.
- handgemacht in Portugal
- ofen- und spülmaschinenfest
- ökologisch und nachhaltig
- robust und beständig
soñho Anoitecer Minischale, 200 ml ist auf Lager und wird versandt, sobald es wieder verfügbar ist
Lieferung innerhalb 2-3 Werktagen
Lieferung innerhalb 2-3 Werktagen
Deine Bestellung erhälst du innerhalb 2-3 Werktagen von uns geliefert.
Versandkostenfrei ab CHF 69.-
Versandkostenfrei ab CHF 69.-
Unsere Versandkosten betragen CHF 7.90 pro Bestellung. Ab einer Bestellung von CHF 69.- ist der Versand kostenfrei.
Kontaktiere uns
Kontaktiere uns
Wir beantworten dir gerne deine Fragen direkt per E-Mail oder telefonisch.
Produktdetails
Produktdetails
Serie: Anoitecer
Farbe: Grau-Weiss gesprenkelt
Material: Steingut
Höhe: 5 cm
Durchmesser: 11 cm
Fassungsvermögen: 200 ml
Artikelnummer: SON25S0044
Material und Pflegehinweise
Material und Pflegehinweise
Steingut, ofen- und spülmaschinenfest